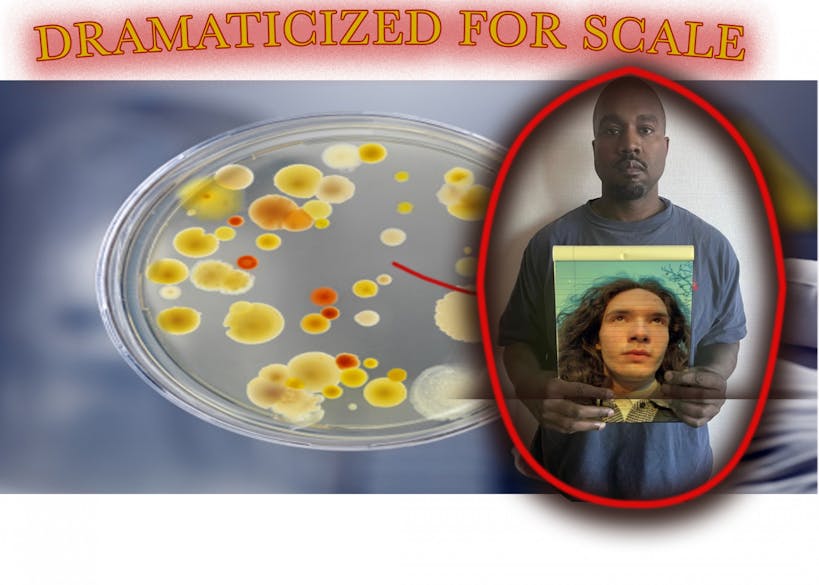

Photo Essay: Is Nobody Going to Comment on My Petiteness?

March 2, 2022 at 11:35 am
Merry Christmas!
I lied. Pagan tradition is not hot.
The James Webb Space Telescope, conveniently launched last Christmas, has caused a cultural reckoning. Why gather around trees when we can gather around our shared devotion of cutting-edge interstellar plunder?
I’m jealous of that metal tube. That lucky bastard. What grandeur, sophistication, and scale! Not just the thing’s size, but scale in terms of the vast distances it will cover in its lifetime.
As I write this in the ravine that is the space between two bricks on Locust Walk, I can only hope to muster the strength to crawl out of this demeaning nook and seek refuge in the Harnwell Lobby, praying a bird doesn’t foil my pursuit and scoop me up for its next meal.
I used to be like you: awaiting the start of a dreaded school week, furrowing my brows a little extra while observing Wilcaf coffee chats, and piggybacking off of jargon in a College Hall philosophy seminar. There’s just one small caveat, if you haven’t already noticed.
I think I’m losing it. Can you not see what I see? The world is crumbling before my micrometer-wide eyes! You repost @penn.memes on your morning stroll to boost your social capital while I rush for cover from the soles of your shoes crashing down on me, marinated in Wharton GSR floor cleaner and Golden Goose calfskin leather!

The facts are loud and clear. I’m laying it out for you word for word. I know you can’t see me, but surely your auditory receptors are registering my clamorous pleas. Should I see if there're any thermal goggles around?
Should I hula-hoop with a Cheerio? Will that elicit a response?

It never used to be like this, you know. Even if it was all a farce, at least I could navigate my life with some dignity. Nowadays, the only thing on my mind is jester’s privilege and my plan of attack as I fend off large protists.
En garde! Prêtes? Allez!
Petite. Small. Microscopic if you like.
There. It’s in the world now.
You probably don't even care about the telescope. You’re shameful for that. If not for my petiteness, rest heavy tonight, the magnitude of magnitudes slapping your cerebrum and sequestering you into REM.
You’re petite too. Ugh. Go away. I can't even look at you anymore.